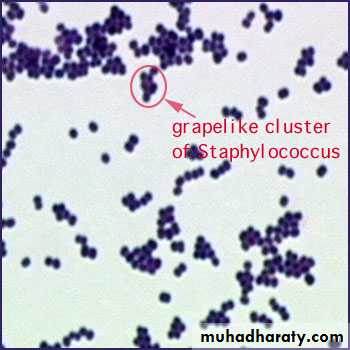
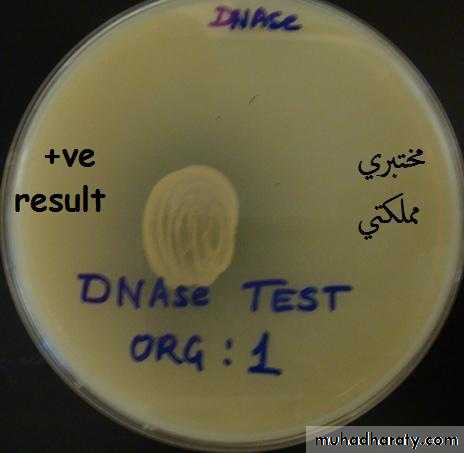
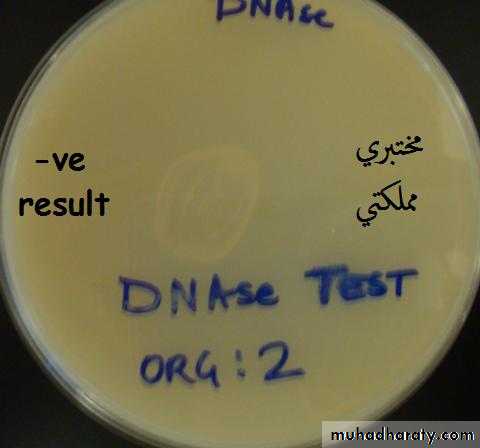
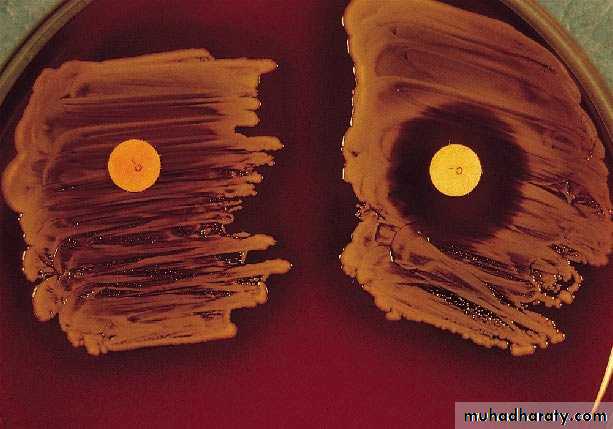
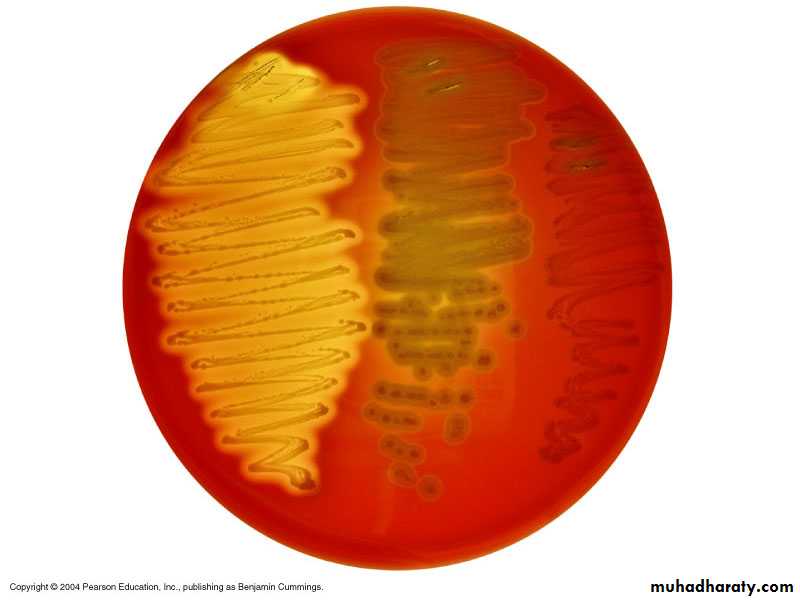
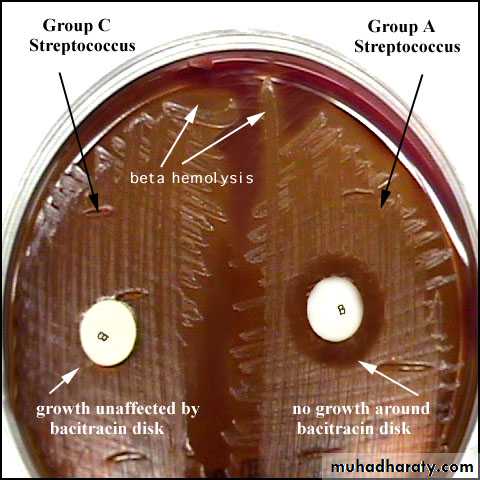
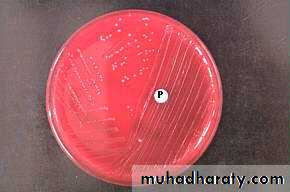
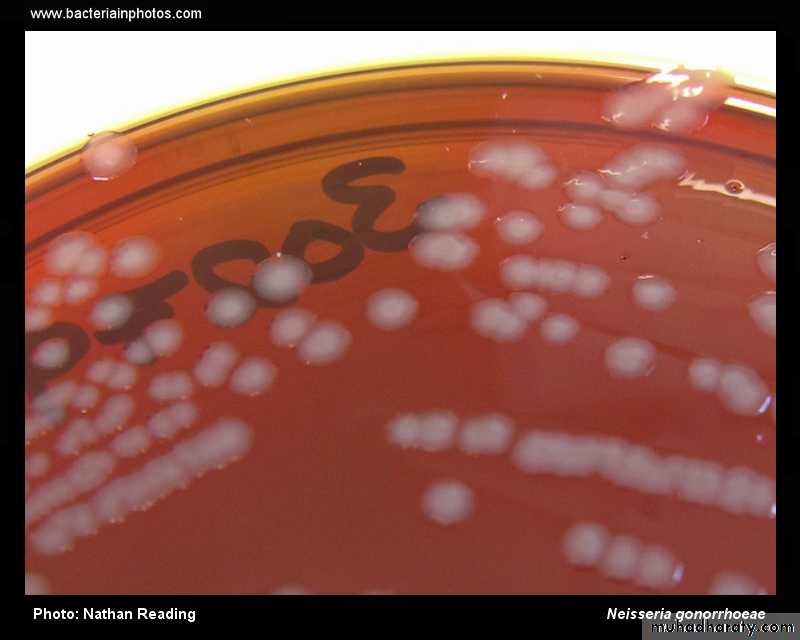
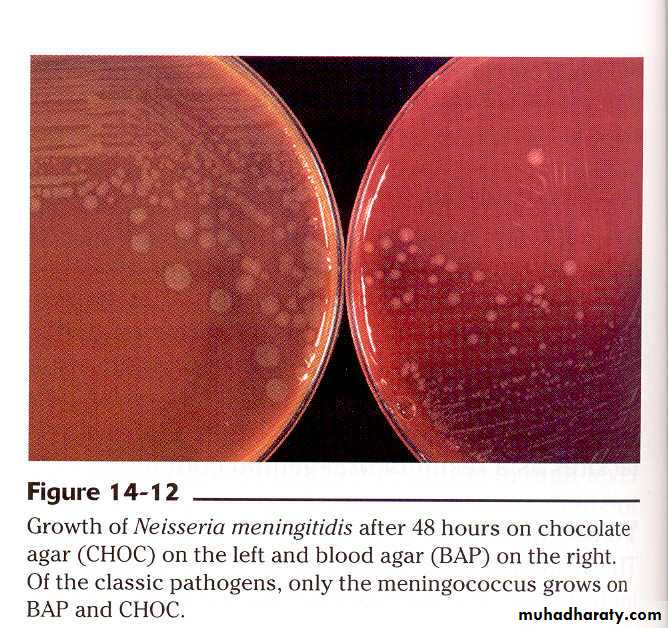
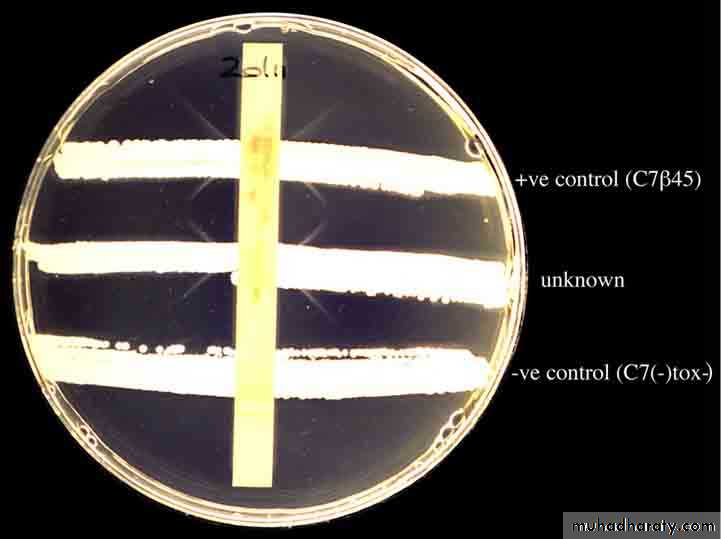
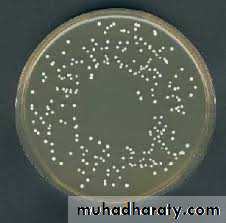
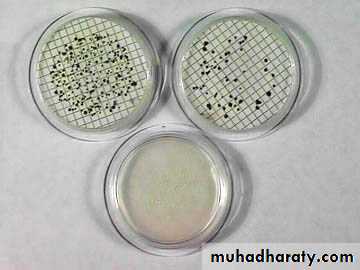
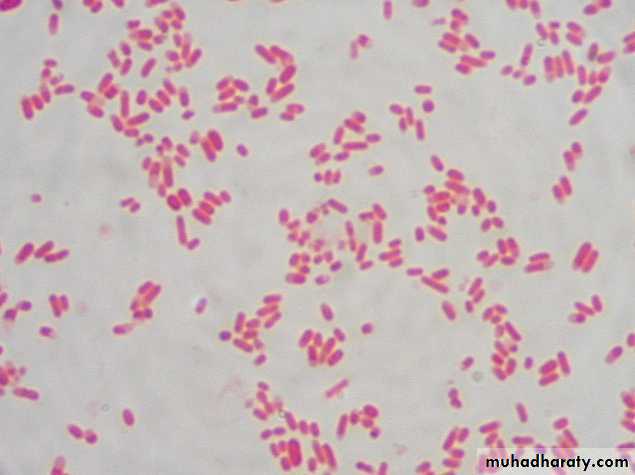
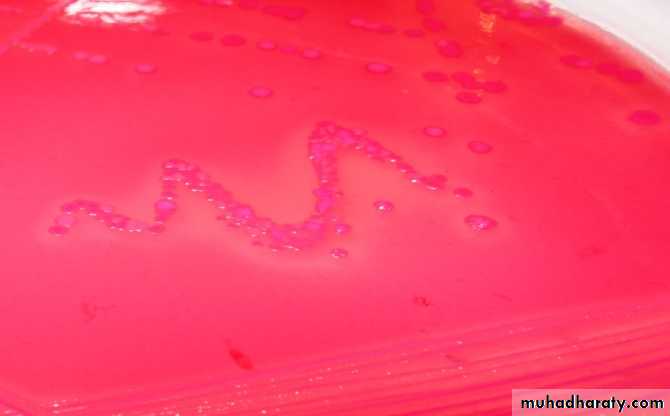
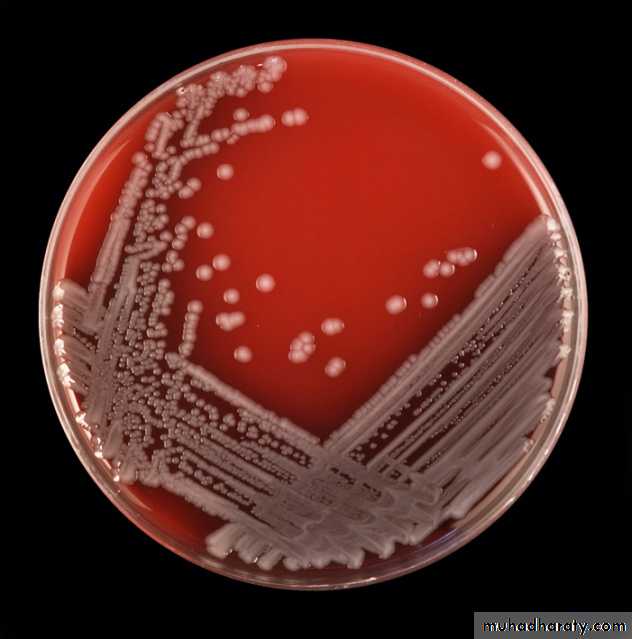
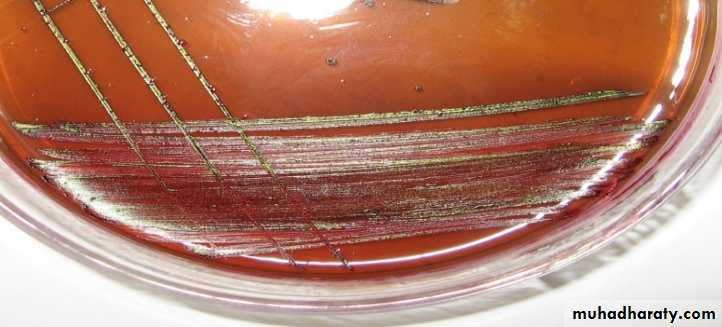
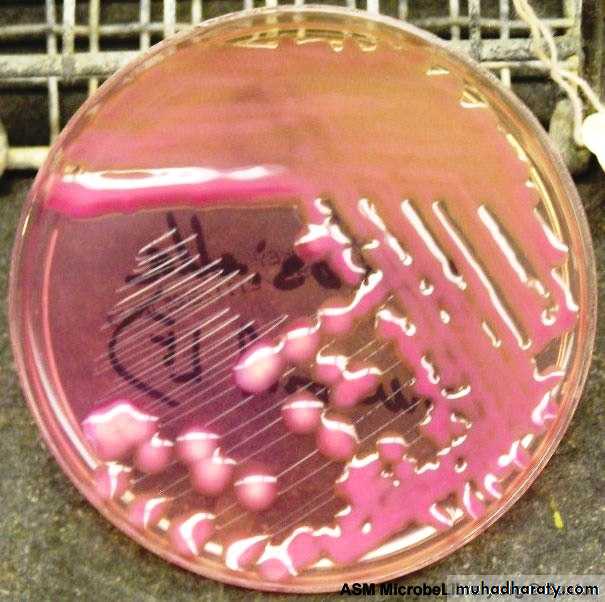
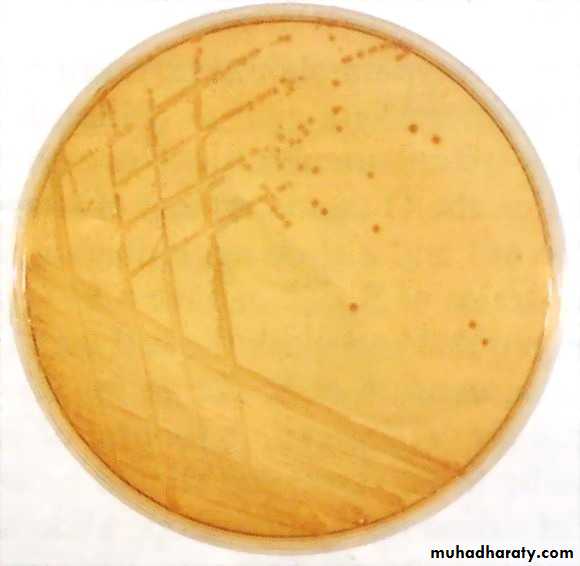
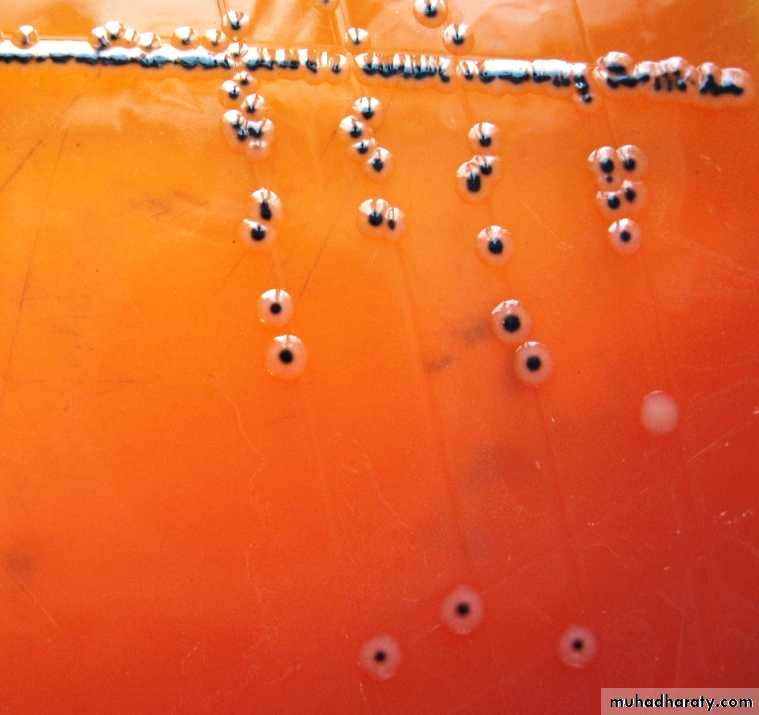
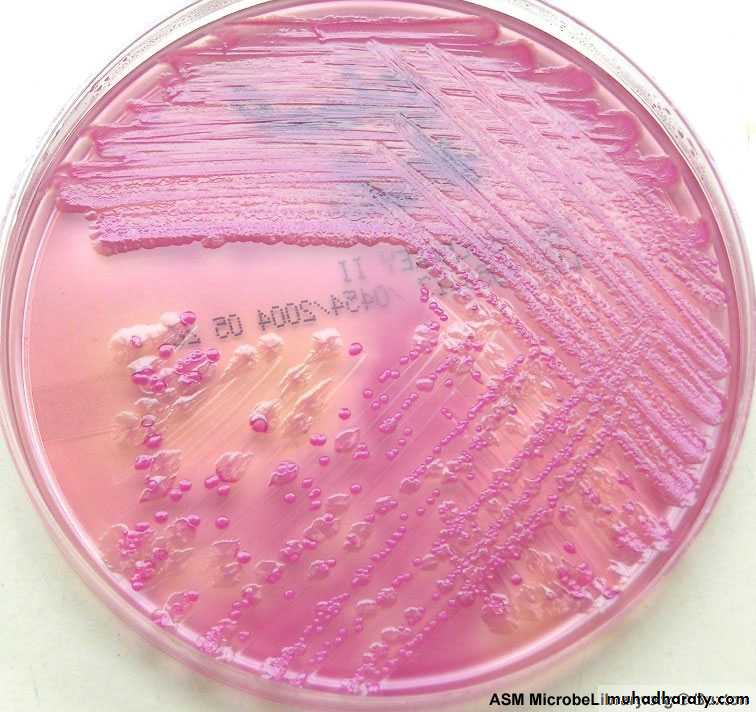
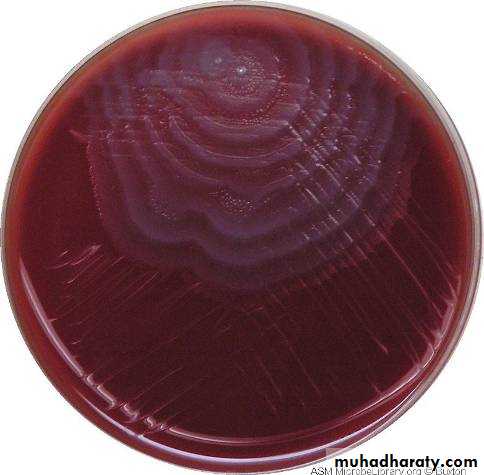
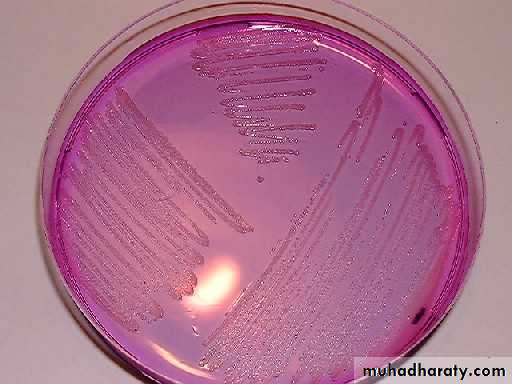
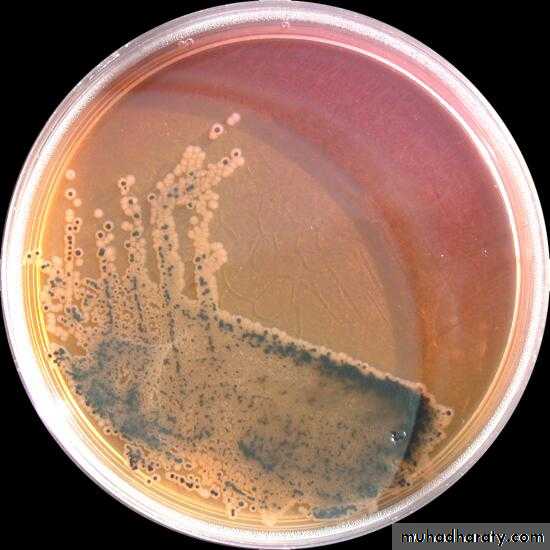
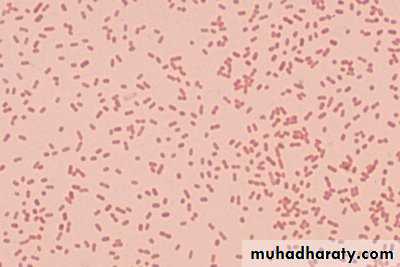
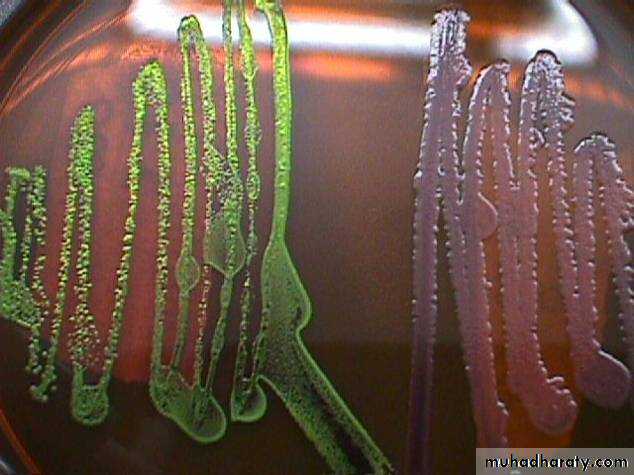
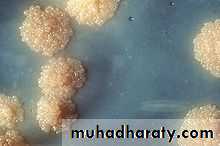

عباره عن صور مختبر المايكرو من المحاضرات فقط جمعتها ووضعتها بهذا الملف
يحتوي على صور مختبرات فقط بعد نصف السنه
هنالك صور قليله مسحوبه من النت
مختبرات 13 و 14 أَخذت من العام الماضي لعم توفرها لدي
Done by me Hassan Almalah
Group – B -
Lab-12-
StaphylococciCatalase tests
• (-) (+)
Coagulase test
Reaction to carbohydrate mannitol.
Dnase test
Novobiocin sensitivity test
Lab-13-
StreptococciStreptococci
a-chains b- pairs (S. Pneumonia)
β-hemolytic Sterptococci.α-hemolytic Sterptococci.Non-hemolytic streptococci
β-hemolytic Sterptococci.• It causes complete hemolysis to RBCs (caused by hemolysins) leading to formation of clear zone around the colonies
• Example: S. pyogenes (group A β-hemolytic Strept.), S.agalactiae
α-hemolytic Sterptococci.
• It causes:
• 1. Zone of greenish discolouration around the colonies.
• Example S.pneumonia ,s.viridans
Bacitracin sensitivity
• Bacitracin will inhibit the growth of gp A Strep. pyogenes giving zone of inhibition around the disk
CAMP test
Optochin Susceptibility Test
Bile Solubility test
Lab-14-
Sterptococcus Pneumoniaebile solubility test
• Result :• + ve clear
• - ve Turbidity
• Lyses of colonies means the microorganism become slouble in bile salt
Optochin disc test ( ethylhydro cupriene
• Result :• If the inhibition zone a greater than 18mm that means its colony of St. pneumoniae while other streptococcus hemolytic hare zone less than 18mm
Quelling reaction ( capsular swelling reaction ) ( Serological test )
• Result :• + ve capsule appear swollen
• - ve capsule quite invisible
Lab 15
neisseriaLab 16
neisseriaAssociated with PMNs
• Intracellular ) )pathogenic Neisseria
• Neisseria (diplococci )appear in electron microscope
Gram stain of N.gonorrhoeaGrowth of N. gonorrhea in the media (Thayer-Martin agar )
Gram stain of Neisseria meningitis
Lab-16
Corynebacterium sppCorynebacterium diphtheria
Loffler slope enriched mediablood tellurite medium
TOXIGENICITYIn vivo
in vitro(Elek’s test)
+ve control
• UnknownLab 17
Lactobacilli• Gram positive lactobacilli
• Lactobacilli under electron microscope
Tomato juice agar (pH 5)
• Tomato juice agar
Rogosa agar• Rogosa agar
Counting of streptococcus mutans and lactobacillus species in the saliva
Snyder test
• Snyder test
Lab 18
EnterobacteriaceaeEscherichia coli
Culture
1-Mac Conkey agar : Pinkcolonies
due to the lactose fermentation
2-Blood agar : Some strains
show beta haemolysis
3-Eosin methylene blue
agar ( EMB ) : green to black
with metallic sheen.
Klebisella Spp.
Klebisella Spp.
Culture :
Blood agar : mucoid colonies .MacConkey agar : large mucoid, pink colonies ( mucoid because accumulation of capsule ) .
Salmonella spp.
Culture :
Mac Conkey agar :Colonies colourless ( NLF )
Salmonella – Shigella agar : brown colonies
with black center ( SS agar ) .Shigella spp
Culture
MacConkey agar : Pale colonies except Sh. sonnei after 48hr .SS agar : Colourless
without black center .
5. Proteus spp.
swarmingpresent only in the absence
of bile salt , .
Culture
1-nutrient agars produce swarming, fishy odor2-urea agar.
Citrobacter :
Citrobacter :
Enterobacter
EMB PLATE: E. coli is seen on the left and E. aerogenes on the right
8.Serratia spp
Lab 19
mycobacterium• Mycobacteria
Sputum testing• Result:
• Acid fast bacteria appear as red• Non-acid fast bacteria appear as blue
Culture
Lowenstein-Jensen medium: special selective media
Lowenstein-Jensen medium: special selective media
(rough, tough, and buff).
Chest x-rayTuberculin skin test (Mantoux skin test):
Tuberculin skin test (Mantoux skin test):
NIACIN TEST
+ve = yellowLab 20
Normal FloraGenus Streptococcus
Genus Stomatococcus
Genus Actinomyces